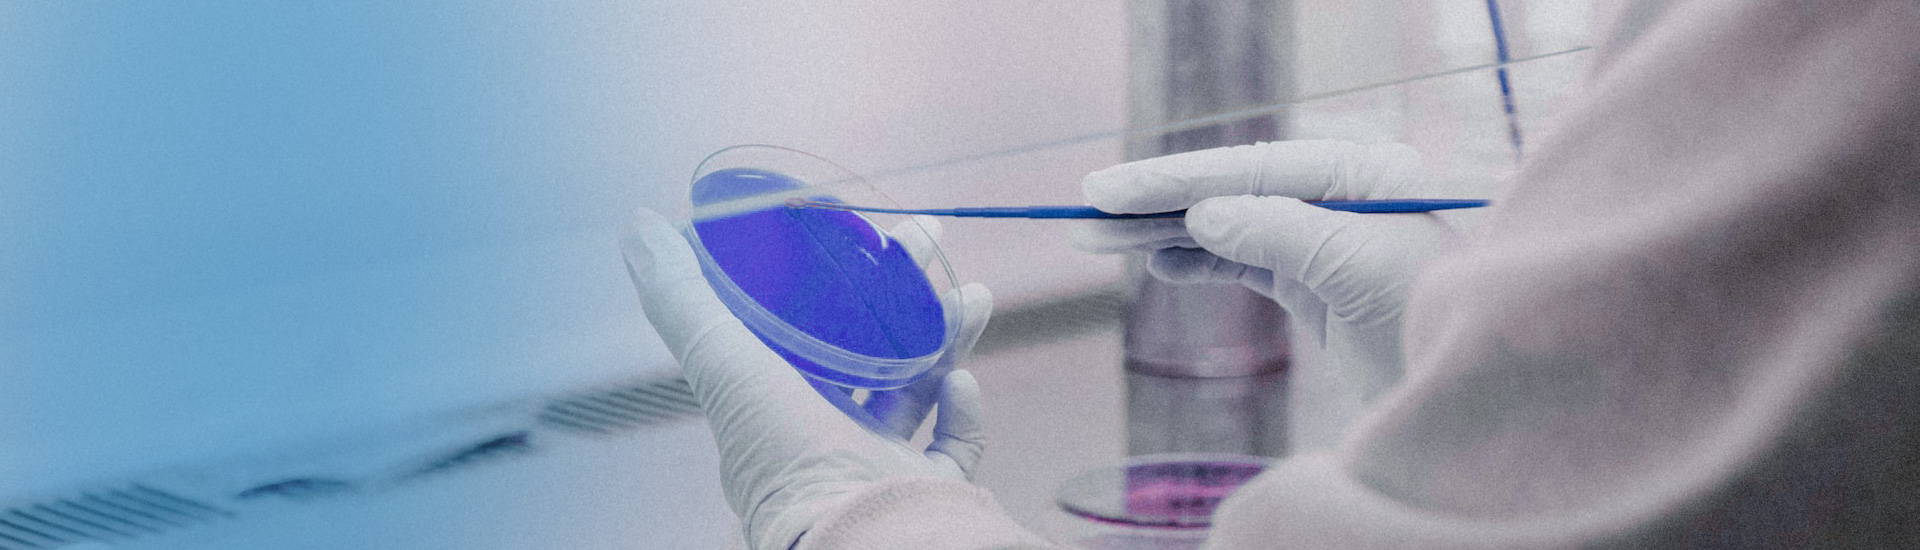

地址:上海市浦东新区康桥镇环桥路555弄27号楼邮箱:BD@neutanpharma.com

原料药和高级中间体开发
具有完善的工艺研发体系平台,聘请多位高校教授担任顾问,常年为项目研发进行技术指导,为科研人员进行技术培训。拥有新药中间体定制、特色仿制药API及高级中间体的开发、生产和销售专业能力。专注于肌松类、抗肿瘤类、抗病毒类、氘代类、造影剂类等产品工艺开发,业务范围遍布国内多个省市,以及包括美国、欧盟、日韩、印度、南美等多个地区。
 设计具有知识产权和成本优势的合成路线
设计具有知识产权和成本优势的合成路线 商业化工艺的开发与优化
商业化工艺的开发与优化 单元操作研究和各步骤关键工艺参数的确认
单元操作研究和各步骤关键工艺参数的确认 杂质的结构、来源以及控制
杂质的结构、来源以及控制

药学研究
团队具有多年的创新药IND和NDA全球注册申报、仿制药的NDA中美申报、国内仿制药一致性评价等相关研究及管理经验。
- 1路线设计及筛选
- 2通过平行反应开展工艺优化,确定工艺参数、过程控制
- 3杂质谱分析、杂质鉴定、合成及标准设定
- 4临床前毒理样品制备
- 5I-III期临床样品制备
- 6应用QbD原则指导工艺开发,如使用DoE工具进行设计空间研究、工艺风险评估
- 7工艺安全测试与评估
- 8生产技术转移
合成技术
-
 金属催化
金属催化 -
 酶催化
酶催化 -
 光化学反应
光化学反应 -
 连续流反应
连续流反应 -
 加氢还原反应
加氢还原反应 -
 药物结晶
药物结晶 -
 精馏分离
精馏分离